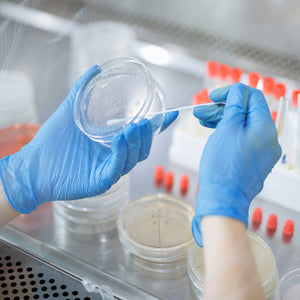

Schneider Disposable Vinyl Synthetic Exam Gloves Case Pack – Blue, 4 Mil, VSFB30 Series, (10) x 100 Count Boxes (1000 Count)


Schneider Disposable Vinyl Synthetic Exam Gloves Case Pack – Blue, 4 Mil, VSFB30 Series, (10) x 100 Count Boxes (1000 Count)



Durable Protection
The Schneider VSFB30 series blue disposable vinyl synthetic exam gloves are made from high-quality, 4-mil thick synthetic vinyl material. This material provides a reliable barrier against unintended substances, making the gloves ideal for use in medical and examination settings. The gloves are designed to withstand the demands of daily use, ensuring that they are durable, compared to traiditional vinyl exam gloves. This makes the gloves a trustworthy choice for healthcare professionals and patients who need reliable protection against various hazards.

Comfortable Fit
Despite their quality construction, the VSFB30 series gloves are designed with comfort in mind. The synthetic vinyl material used is soft, smooth, and flexible, making them easy to put on and take off. The gloves conform to the shape of the hands and fit better than traditional vinyl gloves, providing excellent dexterity and reducing hand fatigue during long procedures. This allows for extended use, making them ideal for healthcare professionals and patients who require comfort and ease of use during medical and examination procedures.

Versatile Use
Whether you are a healthcare professional, food service worker, technician, or janitorial service worker, the VSFB30 series gloves are a versatile solution for all of your needs. Their blue color makes them suitable for use in a variety of settings, and their disposable nature reduces the risk of hazards. Their combination of durability, comfort, and versatility make them an excellent choice for anyone in need of reliable protection and support. The gloves are also cost-effective, making them an economical choice for frequent glove changes.


| Packaging |
Case of 1,000 |
|---|---|
| Size |
Small, Medium, Large, X-Large |